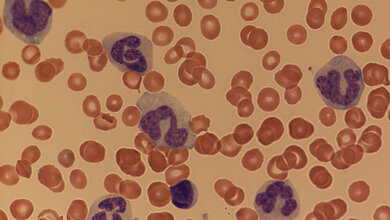
JMML-Patienten

Für Kinder und Erwachsene mit einer Hochrisikoleukämie ist die Stammzelltransplantation eine wichtige Therapieoption. Allerdings besteht bei diesem Austausch des eigenen Immunsystems gegen ein neues blutbildendes System von einem gesunden Spender die Gefahr, dass sich die Spenderzellen gegen den Körper des Patienten richten. Diese Transplantat-gegen-Empfänger-Reaktion, oder auf Englisch Graft-versus-Host-Disease (GvHD), ist besonders tückisch, weil sie ganz unvermittelt auftreten kann und manchmal von einer Infektion nur schwer zu unterscheiden ist. Schwere Verläufe sind lebensbedrohlich.
Vor diesem Hintergrund analysierte ein internationales Konsortium Biomarker im Blut der Patienten, die es erlauben, noch vor dem Auftreten der eigentlichen Probleme Patienten mit hohem Risiko für eine GvHD zu erkennen. Die Ergebnisse wurden Mitte März dieses Jahres veröffentlicht.
Weltweit 23 MAGIC-Zentren
Seit dem Jahr 2014 untersucht das Mt. Sinai Acute GvHD International Consortium, abgekürzt MAGIC, Proben von Kindern und Erwachsenen nach einer Stammzelltransplantation und vergleicht die Ergebnisse mit dem klinischen Verlauf der Patienten. Geleitet von den New Yorker Ärzten Prof. John Levine und Prof. Jamie Ferrara arbeiten weltweit 23 Zentren zusammen. Die Kinderklinik des Uniklinikums Würzburg (UKW) nimmt als bisher einzige Kinderklinik Deutschlands an diesem Projekt teil. Die jungen Patientinnen und Patienten erhalten am UKW ihre Stammzelltransplantationen auf der Station Schatzinsel. Privatdozent Dr. Matthias Wölfl, Oberarzt dieser Station und Coautor des Fachartikels, erläutert die Bedeutung der Forschungserkenntnisse: „Eine schwere GvHD ist wie ein Eisberg: Man sieht nur einen kleinen Teil und den oft auch erst sehr spät. Durch den MAGIC-Algorithmus haben wir jetzt ein Sonar, das uns auch vor den nicht sichtbaren Teilen frühzeitig warnt.“
Proteine als Warnzeichen
Prof. Ferrara und Prof. Levine entdeckten, dass bei einer Transplantat-gegen-Empfänger-Reaktion frühe Schäden im Darm auftreten können, wodurch die Proteine Reg3alpha und ST2 ins Blut abgegeben werden. Auf diesen Markern basiert der Erkennungsalgorithmus, der im internationalen Konsortium getestet wurde. Die sich abzeichnenden Vorteile für die Patienten sind nach Angaben von Dr. Wölfl groß: „Zum einen können Risikopatienten früher als solche erkannt werden und Gegenmaßnahmen intensiviert werden, zum anderen kann bei Patienten ohne Risikofaktoren die intensive immunsupprimierende Therapie schneller reduziert werden.“
Die Arbeit an der Universitätskinderklinik wurde unterstützt durch die Aktion Regenbogen für Leukämie- und Tumorkranke Kinder Main-Tauber e.V. Die deutschen MAGIC-Zentren werden – federführend über das Uniklinikum Regensburg – von der Deutschen José Carreras Leukämie-Stiftung gefördert. (idw, red)
Major-Monfried H, Renteria AS, Pawarode A, et al.: MAGIC biomarkers predict long term outcomes for steroid-resistant acute GVHD. Blood. 2018 Mar 15. pii: blood-2018-01-822957. DOI: 10.1182/blood-2018-01-822957.
Artikel teilen